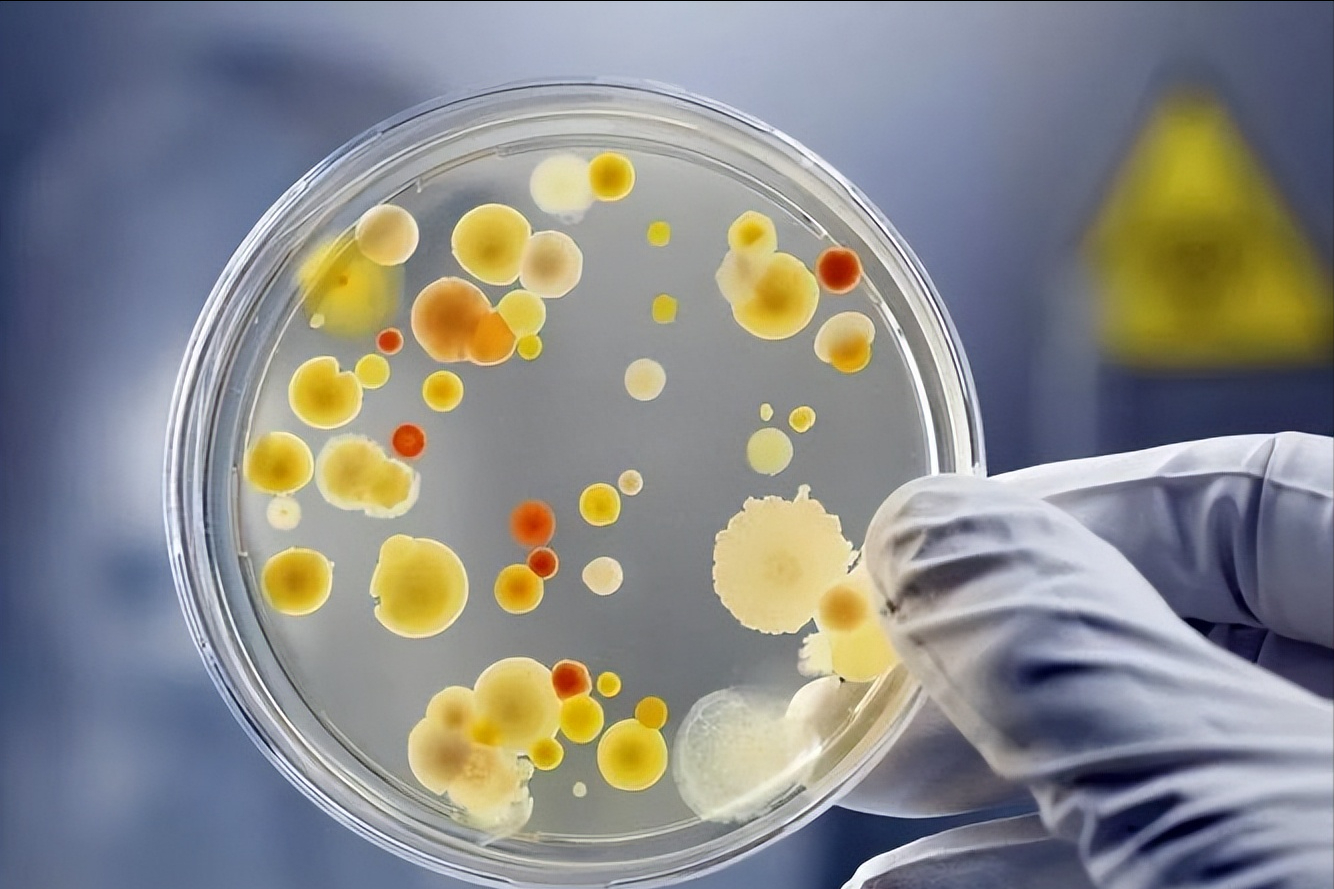

硒酵母片对甲状腺作用(酵母甲状腺片作用硒含量多少)

文 |史记勇者
编辑 |史记勇者
基于硒的吸收和代谢机制,本文重点介绍了有机和无机硒化合物在抗氧化防御中的作用及其潜在的促氧化特性。
基于这些对比作用,进一步探讨硒对畜禽肉品质的影响,为生物富硒技术的研究和富硒产品的开发提供参考。
硒的种类
动物饲料中的硒添加剂分为有机硒和无机硒两种主要形式。
人们普遍认为,硒氨基酸和富硒酵母形式的有机硒在提高生长性能、抗氧化状态和组织硒浓度以及改善牲畜肉质方面比无机硒更有效,这主要是由于其更高的生物利用率和组织保留率。
无机硒以不同价态的硒化合物形式存在,是通过在纳米尺度上调节粒子的形状和大小而设计的无机硒分子,近年来已成为一个有趣的研究课题。

与有机和传统的无机形式相比,硒纳米粒子由于其新颖的性质,如大的比表面积、增加的表面活性和降低的毒性。
然而,硒纳米粒子仍处于发展的初期,在动物和家禽营养中,它们仍是硒的次要来源,在欧洲和美国是不合法的或不受管制的。
对于硒纳米粒子的毒性和添加剂的最佳剂量也提出了一些关注,这需要进一步研究。
硒的吸收和代谢
硒在体内的代谢机制,硒酸盐和亚硒酸盐摄取硒分别通过小肠中的主动转运和被动扩散来实现。吸收后,硒酸盐可以用ATP进行酶促活化,形成腺苷-50-硒代磷酸,要么被硫氧还蛋白或硫氧还蛋白还原酶催化,要么被谷胱甘肽还原酶还原为中间体硒代二谷胱甘肽硫酮,最终生成H2Se。

无机来源的硒与肠道中的其他营养物质重新结合,形成不溶性复合物排出体外,从而减少小肠对硒的吸收。
与无机硒相反,硒蛋氨酸和硒代半胱氨酸的吸收是由氨基酸吸收机制介导的。硒蛋氨酸可能通过转硫途径转化为中间产物Sec,然后分解成了h2Se或经历转氨作用去甲基化成H2Se。
最近,纳米硒转化为亚硒酸盐的可能机制被提出,表明肠道微生物将纳米硒转化为亚硒酸盐、磷酸硒或H2硒,导致选择性蛋白质的合成。

作为两条代谢途径的分支点,H2硒最终转化为硒磷酸盐,为硒蛋白的合成提供活性形式的硒。另一方面,一些硒蛋氨酸掺入硒酶或代替Met参与硒蛋白的合成,从而增加了机体组织中的总硒含量。
因此,通过确定不同硒源可能的代谢途径和吸收过程,可以阐明使用不同硒源对畜产品和人类健康改善程度的差异。
硒的抗氧化机制
据推测,硒的大部分抗氧化作用可能是以催化活性残基硒蛋氨酸的形式存在于解毒活性氧的硒酶。含硒蛋白质,包括谷胱甘肽过氧化物酶,以及硒蛋白,主要涉及维持氧化还原稳态和逆转由氧化应激相关因子诱导的细胞凋亡,表明硒蛋白可以保护细胞免受氧化剂诱导的毒性。

图一,体内硒代谢的机制。二甲基硒醚;真核生物中的硒代半胱氨酸延伸因子;甲基硒醚;SBP2SECIS结合蛋白;仲硒代半胱氨酸;硒蛋氨酸;丝氨酸;三甲基硒鎓。
硒蛋白的翻译受到硒翻译过程的严格控制,这高度依赖于硒的充分利用。

除了存在于酶的催化位点,硒化合物还参与直接氧化还原反应,与多种氧化剂反应的速率常数可能比其硫类似物大,由于离子化硒醇的亲核性质以及Sec和硒蛋氨酸容易氧化。
值得注意的是,越来越多的证据表明超生理硒剂量通过诱导细胞存活所必需的蛋白质巯基的氧化和交联而产生氧自由基,这些相互矛盾的角色对硒在畜牧业生产中的发展和应用提出了新的挑战。
硒基生物营养强化技术的发展
屠宰后,内源性抗氧化系统的崩溃和肌肉向肉转化过程中发生的生化变化被认为是导致肉品质下降的原因。这些变化显著影响蛋白质的物理和化学性质,包括溶解性、持水性和肉的嫩度。
此外,蛋白质氧化降低了氨基酸残基的生物利用率,影响肉类蛋白质的营养价值。

脂质过氧化被认为是破坏细胞膜完整性和色素减少系统的原因,导致肌肉持水能力降低和肉变色以及异味。
越来越多的证据表明,蛋白质和脂质氧化之间的相互作用伴随着导致进一步的氧化。
硒对细胞的抗氧化防御系统非常重要,有助于抵消促氧化因子,防止肉类中的脂质和蛋白质氧化。硒,尤其是它的有机形式,有助于提高总抗氧化能力,避免颜色的变化和不希望的香气形成,这可能是提高畜禽肉品质的基础。
(1)改善肉色

肌红蛋白和其他因素:如脂质氧化之间的生物分子相互作用被广泛接受来共同控制肉的颜色,并且肌红蛋白的自氧化是从亮樱桃红到棕色。
几项研究显示了肉色变化、脂质氧化和蛋白质氧化之间的潜在关系;脂质和蛋白质中发生的氧化反应转移到肌红蛋白部分,从而影响鲜肉的颜色。在这种情况下,补充硒的策略,以提高活性。
(2)增加pH值
屠宰后,无氧呼吸的相对增加导致乳酸的大量积累,导致肌肉pH值的降低,这对肉质指标如嫩度、持水性和色泽。在改善肌肉pH值方面,硒已被证明能提高肌肉细胞清除代谢物乳酸的能力。

它似乎能有效地增强H2O2从而促进肉pH值的增加,用富硒酵母处理后屠宰后24小时,检测到肉的pH值显著增加。与那些观察到的结果一致,其它数据也报道了羟基硒蛋氨酸在由慢性热应激引起的死后低pH中的相反作用。
由于低pH值抑制了肉中的微生物繁殖,富含阿瑟的饮食对于具有较长货架期的肉制品可能是一种良好的营养策略。
然而,一些人报道了使用不同来源的硒所产生的结果,这些研究结果之间的差异很可能是由于硒的剂量和治疗时间、动物种类和饲养管理的差异造成的。
(3)减少滴水损失

细胞骨架蛋白的降解可能导致肌肉细胞肿胀,以保留肌原纤维排出的水分。钙激活的中性蛋白酶:钙蛋白酶的激活导致肉中中间蛋白丝的快速断裂,从而防止整个肌肉细胞膜的收缩。
钙蛋白酶对氧化和pH高度敏感,因为在其活性位点存在组氨酸和含SH的半胱氨酸残基。同时,低pH值抑制了肌肉蛋白结合水的能力,并降低了肌丝之间的负静电排斥,导致肌纤维脱水和收缩。

此外,由自由基诱导的脂质过氧化作用攻击肌肉中的多不饱和脂肪酸,破坏肌肉细胞膜的完整性,这是细胞内液体渗出的主要原因之一。
由se引起的肉抗氧化能力的增加,即GPx合成和活性的增加,减少了钙蛋白酶氧化和膜损伤,从而有助于改善滴水损失,而其他证据强调了激活的钙蛋白酶的抗氧化能力,通过增加pH值和快速降解肌间蛋白来增强肌肉保水能力。
(4)改善肌肉营养成分

越来越多的证据已经描述了Se通过激活Akt和其他负责触发胰岛素信号级联的激酶的胰岛素模拟效应。
相反,硒缺乏诱导的氧化应激增强糖酵解和戊糖磷酸途径,伴随着三羧酸循环的功能障碍,从而调节肝脂肪形成和脂解。硒酸盐的降血糖作用也可能得到其他机制的支持,例如:抑制肠葡萄糖转运和加速肾葡萄糖排泄。

上述机制可能至少是硒的抗氧化作用的部分原因,已经证明硒的抗氧化作用在死后肌肉组织中持续存在。
此外,硒对肌肉蛋白质含量影响的潜在机制似乎涉及由硒蛋白诱导的碘-甲状腺素脱碘酶活性的变化,从而调节甲状腺激素分泌和肌肉能量代谢。
目前,硒对肌肉脂肪含量和脂肪酸组成的影响仍存在争议。

根据Ibrahim等人获得的结果,当使用不同的硒源。与上述效果相反,据报道肌内脂肪的百分比随着SY补充水平的增加而增加。
这一发现与张等人所获得的结果相似,他们报道了与在基础饮食中添加ss的对照组相比,对饮食SY和硒蛋氨酸SS组合均有较高的腹部脂肪含量和背部脂肪厚度。这一发现可以用以下事实来解释。

硒提供了一些营养物质,如维生素、氨基酸和蛋白质,导致脂肪积累的增加。与这些发现相一致,Hassan的一项研究表明,硒的补充以剂量依赖的方式增加了鸡胚成纤维细胞中脂滴的积累,这可能是通过增强CEFs的成脂决定和分化实现的。
此外,抗脂肪分解G0/G1开关的上调和促脂肪分解单酸甘油酯脂肪酶的下调导致硒抑制脂肪分解的作用,进一步支持硒的促脂肪生成作用。
然而,脂质成分的差异也可能导致具有不同感官特性的产品。硒对畜禽肌肉中脂肪和脂肪酸含量的影响及其机理有待进一步研究。
(5)增加肌肉中硒的沉积

在讨论动物产品中硒的富集时,几项使用富含阿瑟饮食的研究表明,在肌肉中有机形式的积累比无机形式的积累更有效。
这些更好的效果背后的机制似乎涉及不同的代谢途径。硒蛋氨酸或者直接代谢成结合在硒蛋白中的反应形式,或者代替蛋白质中的Met,表明有机硒在产肉家畜中能被有效利用并参与硒沉积。
根据一项研究张等人比较了不同硒化合物:蛋氨酸、蛋氨酸和硒酸钠。对肥育猪组织硒含量和硒蛋白基因表达的影响,发现蛋氨酸可以提高硒含量更有效,而MeSeCys在三种形式中增加硒蛋白mRNA表达的效率最高,在肉鸡组织中观察到类似的结果。

此外,索利曼等人得出的结论是,硒在组织中的滞留增加伴随着以0.3毫克/千克饮食的比率补充SeNP,而不是无机硒。目前的结果证实,与无机硒相比,SeNP组织残留物在肝脏和肌肉中消失得更早,这可能归因于纳米颗粒的尺寸。
基于这些结果,有机形式可以用作动物甚至人类硒补充剂的有效来源。这一有希望的证据代表了有机硒应用的开始,最终将完全取代无机硒作为饲料添加剂。

这些结论支持了通过补充动物饲料生产富硒猪肉的潜力,积累硒的动物产品有助于增加平均每日硒摄入量和解决人类营养中硒缺乏的新策略,硒缺乏是一个国家和全球问题。

随着对健康食品需求的增加,人们对安全、高质量、保质期更长的动物产品越来越感兴趣。硒是人类和牲畜健康的必需微量元素,是许多代谢过程所必需的,如抗氧化防御能力、免疫功能和生殖功能,从而有效地降低许多疾病的风险。
世界卫生组织建议成人补硒的每日剂量为55mg,400mg被认为无害。美国食品和营养委员会也承认硒的营养需求随着年龄的变化而变化,从40岁到70岁不等mg男子和45至55岁mg针对女性。
不幸的是,由于食品中硒含量低,人类饮食中硒来源不足已成为全球性问题。相反,来自临床研究的结果表明,通过补充动物饲料使动物源性食物富含硒可能是解决硒缺乏并同时提供一些防癌保护的有效方法。

综上所述,笔者认为,富硒食品吸引了人们的注意,它能在即食产品中提供具有最高生物利用率的有机形式的硒,以补充微量营养素的不足并维持生物体的代谢平衡广泛关注。
